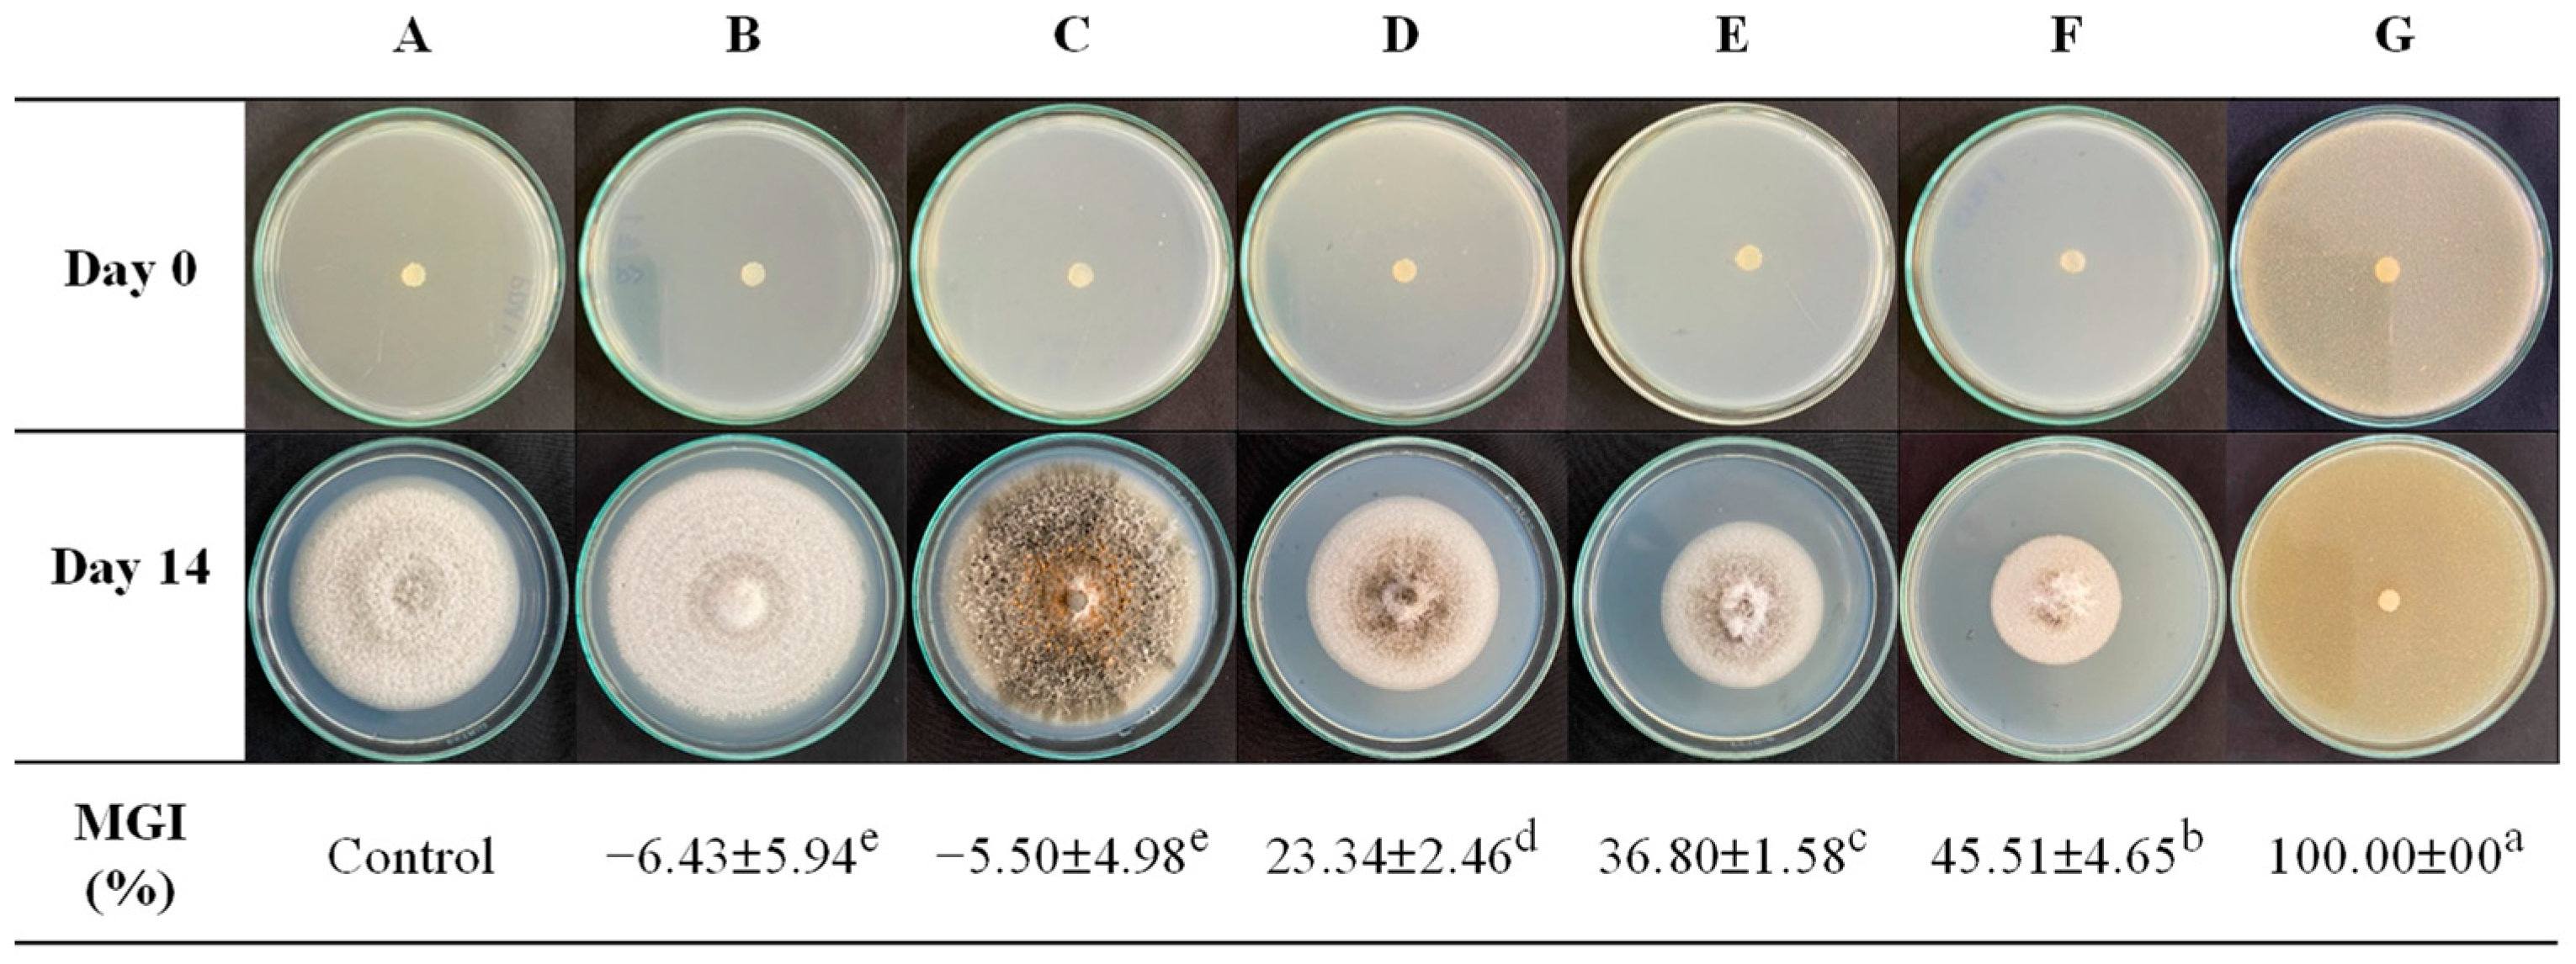
Polymers 16 01375 g001

Impact of Molar Composition on the Functional Properties of Glutinous Rice Starch–Chitosan Blend: Natural-Based Active Coating for Extending Mango Shelf Life
Abstract
:1. Introduction
2. Materials and Methods
2.1. Materials
2.2. Methods
2.2.1. Experiment Part I: Assessing the Effects of Varying Molar Proportions of GRS to Chitosan on GRS/CS Solution and Film Properties
Properties of GRS/CS Blended Solution
- Viscosity
- Effect of coating solution on Colletotrichum gloeosporioides mycelial growth
Morphology, Physical, and Mechanical Properties of GRS/CS Blend Films
- Morphology
- Density
- Water solubility (WS)
- Water contact angle
- Mechanical properties
2.2.2. Experiment Part II: Implementing GRS/CS Active Coatings with Varying Molar Ratios on Mango Surfaces
- Characterization of GRS/CS film coated on mango surface
2.2.3. Statistical Analysis
3. Result and Discussion
3.1. Part I: Effects of Varying Molar Compositions of GRS to Chitosan on GRS/CS Solution and Film Properties
3.1.1. Physical and Chemical Properties of GRS/CS Blend Solutions and Films
3.1.2. Effect of GRS/CS Coating Solution on C. gloeosporioides Mycelial Growth
3.1.3. Morphology of the GRS/CS Blend Films
3.1.4. Water Contact Angle of GRS/CS Film
3.1.5. Mechanical Properties of the GRS/CS Film
3.2. Part II: Implementing GRS/CS Active Coatings with Alternative Molar Ratios on Mango Surfaces
3.2.1. Characterization of GRS/CS Coating on Mango Surface
3.2.2. Quality Aspects of the Mango Coated with GRS/CS
4. Conclusions
Author Contributions
Funding
Institutional Review Board Statement
Data Availability Statement
Acknowledgments
Conflicts of Interest
References
- Kumari, C.; Sharma, M.; Kumar, V.; Sharma, R.; Kumar, V.; Sharma, P.; Irfan, M. Genome editing technology for genetic amelioration of fruits and vegetables for alleviating post-harvest loss. Bioengineering 2022, 9, 176. [Google Scholar] [CrossRef] [PubMed]
- Barbosa, C.H.; Andrade, M.A.; Vilarinho, F.L.; Fernando, A.L.; Silva, A.S. Active edible packaging. Encyclopedia 2021, 1, 360–370. [Google Scholar] [CrossRef]
- Shahbandeh, M. Global Mango Production 2000–2022. 2024. Available online: https://www.statista.com/statistics/577951/world-mango-production/ (accessed on 2 April 2024).
- de Oliveira, K.Á.R.; da Conceição, M.L.; de Oliveira, S.P.A.; Lima, M.D.S.; de Sousa Galvão, M.; Madruga, M.S.; de Souza, E.L. Postharvest quality improvements in mango cultivar Tommy Atkins by chitosan coating with Mentha piperita L. essential oil. J. Hortic. Sci. Biotechnol. 2020, 95, 260–272. [Google Scholar] [CrossRef]
- Hoque, M.I.; Chowhan, S.; Kamruzzaman, M. Physiological changes and shelf life of mango (Mangifera indica L.) Influenced by post harvest treatments. SAARC J. Agric. 2018, 15, 219–226. [Google Scholar] [CrossRef]
- Busatto, N.; Vittani, L.; Farneti, B.; Khomenko, I.; Caffini, M.; Faccini, S.; Costa, F. Physiological and molecular characterization of the late ripening stages in Mangifera indica cv Keitt. Postharvest Biol. Technol. 2022, 183, 111746. [Google Scholar] [CrossRef]
- Rastegar, S.; Hassanzadeh Khankahdani, H.; Rahimzadeh, M. Effectiveness of alginate coating on antioxidant enzymes and biochemical changes during storage of mango fruit. J. Food Biochem. 2019, 43, e12990. [Google Scholar] [CrossRef] [PubMed]
- Ntsoane, M.L.; Zude-Sasse, M.; Mahajan, P.; Sivakumar, D. Quality assesment and postharvest technology of mango: A review of its current status and future perspectives. Sci. Hortic. 2019, 249, 77–85. [Google Scholar] [CrossRef]
- Díaz-Montes, E.; Castro-Muñoz, R. Edible films and coatings as food-quality preservers: An overview. Foods 2021, 10, 249. [Google Scholar] [CrossRef] [PubMed]
- Berihu, H.; Zegeye, A. Enhancement of quality and storability of Avocado (Persea americana) fruit using a blend of aloe vera gel and corn starch as surface coating. Int. J. Food Eng. Technol. 2022, 6, 21. [Google Scholar] [CrossRef]
- Oyom, W.; Xu, H.; Liu, Z.; Long, H.; Li, Y.; Zhang, Z.; Bi, Y.; Tahergorabi, R.; Prusky, D. Effects of modified sweet potato starchedible coating incorporated with cumin essential oil on storage quality of ‘early crisp’. LWT 2022, 153, 12475. [Google Scholar] [CrossRef]
- Ghoshal, G.; Chopra, H. Impact of apricot oil incorporation in tamarind starch/gelatin based edible coating on shelf life of grape fruit. J. Food Meas. Charact. 2022, 16, 1274–1290. [Google Scholar] [CrossRef]
- Rather, J.A.; Makroo, H.A.; Showkat, Q.A.; Majid, D.; Dar, B.N. Recovery of gelatin from poultry waste: Characteristics of the gelatin and lotus starch-based coating material and its application in shelf-life enhancement of fresh cherry tomato. Food Packag. Shelf Life 2022, 31, 100775. [Google Scholar] [CrossRef]
- Cazón, P.; Velazquez, G.; Ramírez, J.A.; Vázquez, M. Polysaccharide-based films and coatings for food packaging: A review. Food Hydrocoll. 2017, 68, 136–148. [Google Scholar] [CrossRef]
- Oladzadabbasabadi, N.; Nafchi, A.M.; Ariffin, F.; Wijekoon, M.J.O.; Al-Hassan, A.A.; Dheyab, M.A.; Ghasemlou, M. Recent advances in extraction, modification, and application of chitosan in packaging industry. Carbohydr. Polym. 2022, 277, 118876. [Google Scholar] [CrossRef]
- Yan, D.; Li, Y.; Liu, Y.; Li, N.; Zhang, X.; Yan, C. Antimicrobial properties of chitosan and chitosan derivatives in the treatment of enteric infections. Molecules 2021, 26, 7136. [Google Scholar] [CrossRef]
- Román-Doval, R.; Torres-Arellanes, S.P.; Tenorio-Barajas, A.Y.; Gómez-Sánchez, A.; Valencia-Lazcano, A.A. Chitosan: Properties and its application in agriculture in context of molecular weight. Polymers 2023, 15, 2867. [Google Scholar] [CrossRef]
- Hesami, A.; Kavoosi, S.; Khademi, R.; Sarikhani, S. Effect of chitosan coating and storage temperature on shelf-life and fruit quality of Ziziphus mauritiana. Int. J. Fruit Sci. 2021, 21, 509–518. [Google Scholar] [CrossRef]
- Saki, M.; ValizadehKaji, B.; Abbasifar, A.; Shahrjerdi, I. Effect of chitosan coating combined with thymol essential oil on physicochemical and qualitative properties of fresh fig (Ficus carica L.) fruit during cold storage. J. Food Meas. Charact. 2019, 13, 1147–1158. [Google Scholar] [CrossRef]
- Parvin, N.; Rahman, A.; Roy, J.; Rashid, M.H.; Paul, N.C.; Mahamud, M.A.; Kader, M.A. Chitosan coating improves postharvest shelf-life of mango (Mangifera indica L.). Horticulturae 2023, 9, 64. [Google Scholar] [CrossRef]
- Ojeda, G.A.; Arias Gorman, A.M.; Sgroppo, S.C.; Zaritzky, N.E. Application of composite cassava starch/chitosan edible coating to extend the shelf life of black mulberries. J. Food Process. Preserv. 2021, 45, e15073. [Google Scholar] [CrossRef]
- Shapi’i, R.A.; Othman, S.H.; Nordin, N.; Basha, R.K.; Naim, M.N. Antimicrobial properties of starch films incorporated with chitosan nanoparticles: In vitro and in vivo evaluation. Carbohydr. Polym. 2020, 230, 115602. [Google Scholar] [CrossRef] [PubMed]
- da Costa, J.C.M.; Miki, K.S.L.; da Silva Ramos, A.; Teixeira-Costa, B.E. Development of biodegradable films based on purple yam starch/chitosan for food application. Heliyon 2020, 6, 4. [Google Scholar]
- Lee, H.M.; Kim, M.H.; Yoon, Y.I.; Park, W.H. Fluorescent property of chitosan oligomer and its application as a metal ion sensor. Mar. Drugs 2017, 15, 105. [Google Scholar] [CrossRef] [PubMed]
- ASTM D882-12; Standard Test Method for Tensile Properties of Thin Plastic Sheeting. ASTM International: West Conshohocken, PA, USA, 2012.
- Wongkaew, M.; Sangta, J.; Chansakaow, S.; Jantanasakulwong, K.; Rachtanapun, P.; Sommano, S.R. Volatile profiles from over-ripe purée of Thai mango varieties and their physiochemical properties during heat processing. PLoS ONE 2021, 16, e0248657. [Google Scholar] [CrossRef] [PubMed]
- Kim, K.M.; Son, J.H.; Kim, S.K.; Weller, C.L.; Hanna, M.A. Properties of Chitosan Films as a Function of pH and Solvent Type. J. Food Sci. E Food Eng. Phys. Prop. 2006, 71, 119–124. [Google Scholar] [CrossRef]
- Xu, J.; Liu, K.; Chang, W.; Chiou, B.S.; Chen, M.; Liu, F. Regulating the Physicochemical Properties of Chitosan Films through Concentration and Neutralization. Foods 2022, 11, 1657. [Google Scholar] [CrossRef]
- Abidin, M.Z.A.Z.; Julkapli, N.M.; Juahir, H.; Azaman, F.; Abidin, I.Z.; Sulaiman, N.H. Fabrication and properties of chitosan with starch for packaging application. Malays. J. Anal. Sci. 2015, 19, 1032–1042. [Google Scholar]
- Juliano, B.O. The chemical basis of rice grain quality. In Proceedings of the Workshop on Chemical Aspects of Rice Grain Quality; International Rice Research Institute: Los Baños, Laguna, Philippines, 1979; pp. 69–90. [Google Scholar]
- Pfister, B.; Zeeman, S.C.; Rugen, M.D.; Field, R.A.; Ebenhöh, O.; Raquin, A. Theoretical and experimental approaches to understand the biosynthesis of starch granules in a physiological context. Photosynth. Res. 2020, 145, 55–70. [Google Scholar] [CrossRef] [PubMed]
- Mathew, S.; Brahmakumar, M.; Abraham, T.E. Microstructural imaging and characterization of the mechanical, chemical, thermal, and swelling properties of starch–chitosan blend films. Biopolymers 2006, 82, 176–187. [Google Scholar] [CrossRef]
- Seo, S. Depolymerization and Decolorization of Chitosan by Ozone Treatment. Master’s Thesis, Louisiana State University and Agricultural and Mechanical College, Baton Rouge, LA, USA, 2006. [Google Scholar]
- Bilbao-Sainz, C.; Sen Chiou, B.; Williams, T.; Wood, D.; Du, W.X.; Sedej, I.; Ban, Z.; Rodov, V.; Poverenov, E.; Vinokur, Y.; et al. Vitamin D-fortified chitosan films from mushroom waste. Carbohydr. Polym. 2017, 167, 97–104. [Google Scholar] [CrossRef]
- Ibrahim, M.I.J.; Sapuan, S.M.; Zainudin, E.S.; Zuhri, M.Y.M. Physical, thermal, morphological, and tensile properties of cornstarch-based films as affected by different plasticizers. Int. J. Food Prop. 2019, 22, 925–941. [Google Scholar] [CrossRef]
- Sharma, M.; Kulshrestha, S. Colletotrichum gloeosporioides: An anthracnose causing pathogen of fruits and vegetables. Biosci. Biotechnol. Res. Asia 2015, 12, 1233–1246. [Google Scholar] [CrossRef]
- Le, T.D.; Viet Nguyen, T.; Muoi, N.V.; Toan, H.T.; Lan, N.M.; Pham, T.N. Supply chain management of Mango (Mangifera indica L.) fruit: A review with a focus on product quality during postharvest. Front. Sustain. Food Syst. 2022, 5, 799431. [Google Scholar] [CrossRef]
- Marques, K.M.; Galati, V.C.; Fernandes, J.D.R.; Guimarães, J.E.R.; Silva, J.P.; Mattiuz, B.H.; Mattiuz, C.F.M. Use of chitosan for the control of postharvest anthracnose and quality in avocados. Acta Hortic. 2016, 1120, 225–231. [Google Scholar] [CrossRef]
- Edirisinghe, M.; Ali, A.; Maqbool, M.; Alderson, P.G. Chitosan controls postharvest anthracnose in bell pepper by activating defense-related enzymes. J. Food Sci. Technol. 2014, 51, 4078–4083. [Google Scholar] [CrossRef]
- Ayón Reyna, L.E.; Uriarte Gastelum, Y.G.; Camacho Díaz, B.H.; Tapia Maruri, D.; López López, M.E.; López Velázquez, J.G.; Vega Garcia, M.O. Antifungal activity of a chitosan and mint essential oil coating on the development of Colletotrichum gloeosporioides in papaya using macroscopic and microscopic analysis. Food Bioprocess Technol. 2022, 15, 368–378. [Google Scholar] [CrossRef]
- Limon, T.; Birke, A.; Monribot-Villanueva, J.L.; Guerrero-Analco, J.A.; Altúzar-Molina, A.; Carrión, G.; Aluja, M. Chitosan coatings reduce fruit fly (Anastrepha obliqua) infestation and development of the fungus Colletotrichum gloeosporioides in Manila mangoes. J. Sci. Food Agric. 2021, 101, 2756–2766. [Google Scholar] [CrossRef]
- Qin, Y.; Li, P.; Guo, Z. Cationic chitosan derivatives as potential antifungals: A review of structural optimization and applications. Carbohydr. Polym. 2020, 236, 116002. [Google Scholar] [CrossRef]
- Lopez-Moya, F.; Suarez-Fernandez, M.; Lopez-Llorca, L.V. Molecular mechanisms of chitosan interactions with fungi and plants. Int. J. Mol. Sci. 2019, 20, 332. [Google Scholar] [CrossRef]
- Goehring, L. Drying and cracking mechanisms in a starch slurry. Phys. Rev. E 2009, 80, 036116–036125. [Google Scholar] [CrossRef]
- Izawa, H.; Ishisaka, S.; Saimoto, H.; Ifuku, S. Drying-Induced Surface Wrinkles Generated on Chitosan Films Having Polyion Complex Skin Layers: Effects of Physical Properties of Skin Layers and Substrates on Surface Wrinkling upon Drying. Bull. Chem. Soc. Jpn. 2022, 95, 1289–1295. [Google Scholar] [CrossRef]
- Morawetz, H. On the versatility of fluorescence techniques in polymer research. J. Polym. Sci. Part A Polym. Chem. 1999, 37, 1725–1735. [Google Scholar] [CrossRef]
- Roman, M.; Nechita, P.; Vasile, M.-A.; Cantaragiu Ceoromila, A.-M. Barrier and Antimicrobial Properties of Coatings Based on Xylan Derivatives and Chitosan for Food Packaging Papers. Coatings 2023, 13, 1761. [Google Scholar] [CrossRef]
- Wongs-Aree, C.; Nguyen, H.T.; Noichinda, S. Improved Postharvest Techniques for Fruit Coatings. In New Advances in Postharvest Technology; İbrahim Kahramanoğlu; IntechOpen: Rijeka, Croatia, 2023; ISBN 9781837685424. [Google Scholar]
- Bertuzzi, M.A.; Castro Vidaurre, E.F.; Armada, M.; Gottifredi, J.C. Water vapor permeability of edible starch based films. J. Food Eng. 2007, 80, 972–978. [Google Scholar] [CrossRef]
- Mangaraj, S.; Goswami, T.K.; Panda, D.K. Modeling of gas transmission properties of polymeric films used for MA packaging of fruits. J. Food Sci. Technol. 2015, 52, 5456–5469. [Google Scholar] [CrossRef]
- Luchese, C.L.; Pavoni, J.M.F.; Dos Santos, N.Z.; Quines, L.K.; Pollo, L.D.; Spada, J.C.; Tessaro, I.C. Effect of chitosan addition on the properties of films prepared with corn and cassava starches. J. Food Sci. Technol. 2018, 55, 2963–2973. [Google Scholar] [CrossRef]
- Fadiji, T.; Rashvand, M.; Daramola, M.O.; Iwarere, S.A. A Review on Antimicrobial Packaging for Extending the Shelf Life of Food. Processes 2023, 11, 590. [Google Scholar] [CrossRef]
- Mitchell, J.R.; MacNaughtan, W.; Foster, T.J.; Harabagiu, V.; Song, Y.; Zheng, Q. Comparison of the Mechanical Properties of Cellulose and Starch Films. Biomacromolecules 2010, 11, 126–132. [Google Scholar]
- Bertoft, E. Understanding Starch Structure: Recent Progress. Agronomy 2017, 7, 56. [Google Scholar] [CrossRef]
- D’Angelo, G.; Elhussieny, A.; Faisal, M.; Fahim, I.S.; Everitt, N.M. Mechanical Behavior Optimization of Chitosan Extracted from Shrimp Shells as a Sustainable Material for Shopping Bags. J. Funct. Biomater. 2018, 9, 37. [Google Scholar] [CrossRef]
- Prasad, K.; Sharma, R.R.; Srivastav, M. Postharvest treatment of antioxidant reduces lenticel browning and improves cosmetic appeal of mango (Mangifera indica L.) fruits without impairing quality. J. Food Sci. Technol. 2016, 53, 2995–3001. [Google Scholar]
- Bansal, H.; Singh, S.; Sharma, A.; Sundaramurthy, S.; Mehta, S.K. Polymer nanocomposite films and coatings for antimicrobial and antifungal applications. In Polymer Nanocomposite Films and Coatings, 1st ed.; Pandey, M., Deshmukh, K., Eds.; Woodhead Publishing: Cambridge, UK, 2024; pp. 785–815. [Google Scholar]
- Heredia-Guerrero, J.A.; Benítez, J.J.; Domínguez, E.; Bayer, I.S.; Cingolani, R.; Athanassiou, A.; Heredia, A. Infrared and Raman spectroscopic features of plant cuticles: A review. Front. Plant Sci. 2014, 5, 305–310. [Google Scholar] [CrossRef]
- Prinsloo, L.C.; du Plooy, W.; van der Merwe, C. Raman spectroscopic study of the epicuticular wax layer of mature mango (Mangifera indica) fruit. J. Raman Spectrosc. 2004, 35, 561–567. [Google Scholar] [CrossRef]
- Dubis, E.N.; Dubis, A.T.; Morzycki, J.W. Comparative analysis of plant cuticular waxes using HATR FT-IR reflection technique. J. Mol. Struct. 1999, 511, 173–179. [Google Scholar] [CrossRef]
- Kizil, R.; Irudayaraj, J.; Seetharaman, K. Characterization of irradiated starches by using FT-Raman and FTIR spectroscopy. J. Agric. Food Chem. 2002, 50, 3912–3918. [Google Scholar] [CrossRef]
- Soe, M.T.; Pongjanyakul, T.; Limpongsa, E.; Jaipakdee, N. Films Fabricated with Native and Ball-Milled Modified Glutinous Rice Starch: Physicochemical and Mucoadhesive Properties. Starch 2021, 73, 2000012. [Google Scholar] [CrossRef]
- Wang, S.; Wang, J.; Zhang, W.; Li, C.; Yu, J.; Wang, S. Molecular order and functional properties of starches from three waxy wheat varieties grown in China. Food Chem. 2015, 181, 43–50. [Google Scholar] [CrossRef]
- Xu, Y.X.; Kim, K.M.; Hanna, M.A.; Nag, D. Chitosan–starch composite film: Preparation and characterization. Ind. Crops Prod. 2005, 21, 185–192. [Google Scholar] [CrossRef]
- Rakkapao, N.; Vao-Soongnern, V.; Masubuchi, Y.; Watanabe, H. Miscibility of chitosan/poly (ethylene oxide) blends and effect of doping alkali and alkali earth metal ions on chitosan/PEO interaction. Polymers 2011, 52, 2618–2627. [Google Scholar] [CrossRef]
- Gieroba, B.; Sroka-Bartnicka, A.; Kazimierczak, P.; Kalisz, G.; Lewalska-Graczyk, A.; Vivcharenko, V.; Przekora, A. Surface chemical and morphological analysis of chitosan/1, 3-β-d-glucan polysaccharide films cross-linked at 90 °C. Int. J. Mol. Sci. 2022, 23, 5953. [Google Scholar] [CrossRef]
- Queiroz, M.F.; Melo, K.R.T.; Sabry, D.A.; Sassaki, G.L.; Rocha, H.A.O. Does the use of chitosan contribute to oxalate kidney stone formation? Mar. Drugs 2014, 13, 141–158. [Google Scholar] [CrossRef]
- Hadthamard, N.; Chaumpluk, P.; Buanong, M.; Boonyaritthongchai, P.; Wongs-Aree, C. Effects of Multilayer Coating of Chitosan and Polystyrene Sulfonate on Quality of ‘Nam Dok Mai No. 4’ Mango. Int. J. Agric. Biosyst. Eng. 2019, 13, 42–48. [Google Scholar]
- Felicia, W.X.L.; Rovina, K.; Nur’Aqilah, M.N.; Vonnie, J.M.; Erna, K.H.; Misson, M.; Halid, N.F.A. Recent advancements of polysaccharides to enhance quality and delay ripening of fresh produce: A review. Polymers 2022, 14, 1341. [Google Scholar] [CrossRef] [PubMed]
- Kumari, M.; Mahajan, H.; Joshi, R.; Gupta, M. Development and structural characterization of edible films for improving fruit quality. Food Packag. Shelf-Life 2017, 12, 42–50. [Google Scholar] [CrossRef]
- Jongsri, P.; Wangsomboondee, T.; Rojsitthisak, P.; Seraypheap, K. Effect of molecular weights of chitosan coating on postharvest quality and physicochemical characteristics of mango fruit. LWT-Food Sci. Technol. 2016, 73, 28–36. [Google Scholar] [CrossRef]
- Wongkhot, A.; Rattanapanone, N.; Chanasut, U. BrimA, total acidity and total soluble solids correlate to total carotenoid content as indicators of the ripening process of six thai mango fruit cultivars. Chiang Mai Univ. J. Nat. Sci. 2012, 11, 97–103. [Google Scholar]
- Silva, G.M.C.; Silva, W.B.; Medeiros, D.B.; Salvador, A.R.; Cordeiro, M.H.M.; da Silva, N.M.; Santana, D.B.; Mizobutsi, G.P. The chitosan affects severely the carbon metabolism in mango (Mangifera indica L. cv. Palmer) fruit during storage. Food Chem. 2017, 237, 372–378. [Google Scholar] [CrossRef]

| Sample Named | Ratio of GRS and Chitosan | Weight of GRS and Chitosan | Volume of Solvent | |||
|---|---|---|---|---|---|---|
| (%mol) | (g) | (mL) | ||||
| GRS | Chitosan | GRS | Chitosan | H2O | CH3COOH | |
| (0.1 M) | ||||||
| GRS100/CS0 | 100 | 0 | 1.98 | 0.00 | 100 | 0 |
| GRS70/CS30 | 70 | 30 | 1.39 | 0.60 | 70 | 30 |
| GRS50/CS50 | 50 | 50 | 0.99 | 1.00 | 50 | 50 |
| GRS30/CS70 | 30 | 70 | 0.60 | 1.40 | 30 | 70 |
| GRS0/CS100 | 0 | 100 | 0.00 | 2.00 | 0 | 100 |
| Properties | GRS100/CS0 | GRS70/CS30 | GRS50/CS50 | GRS30/CS70 | GRS0/CS100 | |
|---|---|---|---|---|---|---|
| Solution | pH | 6.81 ± 0.03 | 5.63 ± 0.07 | 5.22 ± 0.11 | 4.55 ± 0.08 | 3.68 ± 0.04 |
| Viscosity (cP) at 29 ± 1 °C | 27.3 ± 0.8 | 34.5 ± 0.5 | 66.5 ± 0.7 | 136.5 ± 0.4 | 667.5 ± 0.6 | |
| Film | Appearance of film |  |  |  |  |  |
| Density (g/cm3) | 1.88 ± 0.12 | 1.61 ± 0.08 | 1.53 ± 0.06 | 1.41 ± 0.03 | 1.09 ± 0.10 | |
| Water solubility (%) | N/A | N/A | 26.75 ± 0.50 | 19.94 ± 1.12 | 12.31 ± 0.59 | |
Disclaimer/Publisher’s Note: The statements, opinions and data contained in all publications are solely those of the individual author(s) and contributor(s) and not of MDPI and/or the editor(s). MDPI and/or the editor(s) disclaim responsibility for any injury to people or property resulting from any ideas, methods, instructions or products referred to in the content. |
© 2024 by the authors. Licensee MDPI, Basel, Switzerland. This article is an open access article distributed under the terms and conditions of the Creative Commons Attribution (CC BY) license (https://creativecommons.org/licenses/by/4.0/).
Share and Cite
Nitikornwarakul, C.; Wangpradid, R.; Rakkapao, N. Impact of Molar Composition on the Functional Properties of Glutinous Rice Starch–Chitosan Blend: Natural-Based Active Coating for Extending Mango Shelf Life. Polymers 2024, 16, 1375. https://doi.org/10.3390/polym16101375
Nitikornwarakul C, Wangpradid R, Rakkapao N. Impact of Molar Composition on the Functional Properties of Glutinous Rice Starch–Chitosan Blend: Natural-Based Active Coating for Extending Mango Shelf Life. Polymers. 2024; 16(10):1375. https://doi.org/10.3390/polym16101375
Chicago/Turabian StyleNitikornwarakul, Chawakwan, Rodjanawan Wangpradid, and Natthida Rakkapao. 2024. "Impact of Molar Composition on the Functional Properties of Glutinous Rice Starch–Chitosan Blend: Natural-Based Active Coating for Extending Mango Shelf Life" Polymers 16, no. 10: 1375. https://doi.org/10.3390/polym16101375








